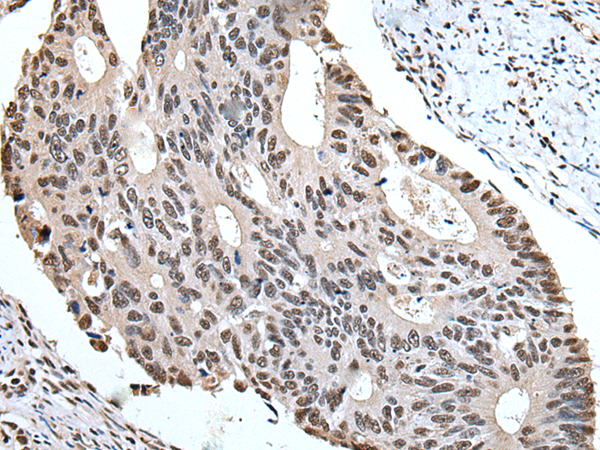

中文名稱: 兔抗ZBTB10多克隆抗體
技術(shù)規(guī)格
Background:
RINZF, also known as ZBTB10 (zinc finger and BTB domain containing protein 10), is a 847 amino acid protein that contains one BTB/POZ domain and two C2H2-type zinc fingers. Localized to the nucleus, RINZF is believed to play a role in transcriptional regulation. Specifically, RINZF is capable of binding to the CACC element of the Gastrin promoter. In this regard, RINZF competes with Sp1 for CACC binding and interferes with Sp1 transactivation, thereby regulating Gastrin gene expression. The rat RINZF protein shares 98% homology with the human RINZF protein, suggesting that RINZF is a conserved protein. Due to alternative splicing events, two RINZF isoforms exist. In addition, RINZF may be phosphorylated by ATR or ATM upon DNA damage.
Applications:
ELISA, WB, IHC
Name of antibody:
ZBTB10
Immunogen:
Synthetic peptide of human ZBTB10
Full name:
zinc finger and BTB domain containing 10
Synonyms:
RINZF
SwissProt:
Q96DT7
ELISA Recommended dilution:
5000-10000
IHC positive control:
Human colorectal cancer and human tonsil
IHC Recommend dilution:
50-300
WB Predicted band size:
95 kDa
WB Positive control:
Jurkat cell lysate
WB Recommended dilution:
500-2000

購物車
幫助
021-54845833/15800441009
